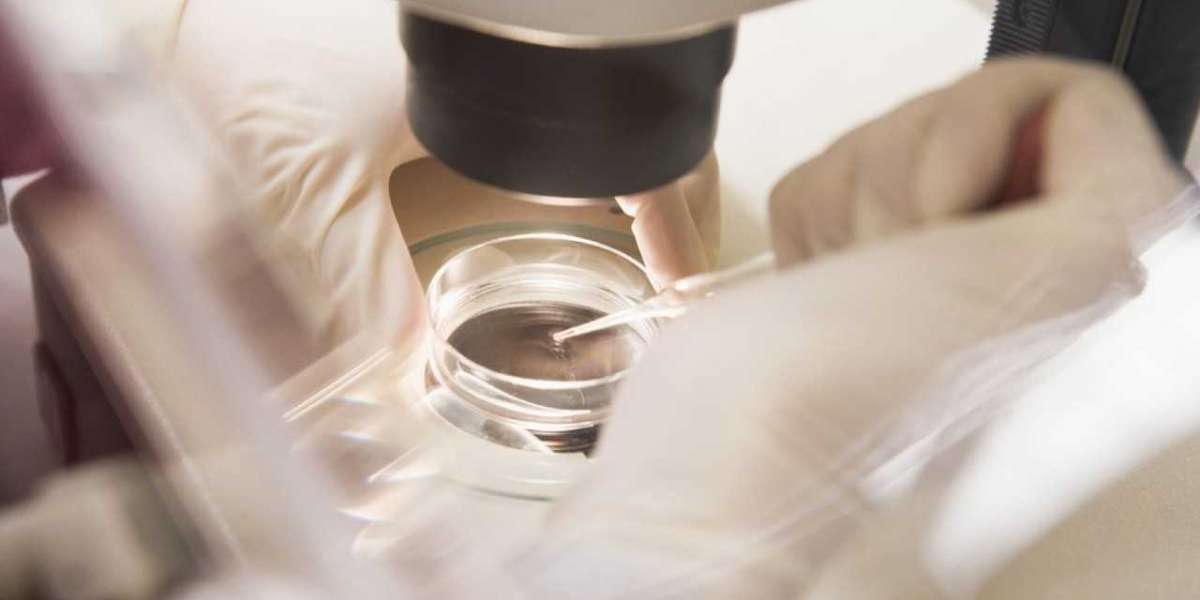
Article Picture

Reddy Anna Book stands as one of the most trusted online sports betting platforms which caters to sport enthusiasts in the digital domain. ReddyAnna features a safe betting platform which accommodates users who bet on cricket and football matches and casino activities.
Why Choose Reddy Anna Book?
1. Instant Cricket ID Registration
Using ReddyAnna for the first time remains easy to do. Users can achieve Cricket ID registration immediately by using WhatsApp and Telegram platforms as well as live chat platforms. Anyone with a small deposit amount can begin betting immediately because the account becomes active.
2. Wide Range of Betting Options
The book offers betting opportunities on multiple sports which include Cricket and Football together with Tennis and Kabaddi and Horse Racing.
Cricket
Football
Tennis
Kabaddi
Horse Racing
The gaming experience at ReddyAnna includes Rummy and Teen Patti and Roulette which are accessible through live casino games.
3. User-Friendly Interface
Users can move through pages effortlessly since Reddy Anna Book provides its interface with a basic yet user-friendly design that works equally well for novel users.
4. Safe and Secure Transactions
Customers of ReddyAnna can process their money safely through UPI and Paytm as well as traditional withdrawal and deposit options.
5. 24/7 Customer Support
Reddy Anna Book maintains constant customer service availability through WhatsApp and Telegram channels as well as the access to live chat.
- A step-by-step guide to signing up on Reddy Anna Book includes the following procedure.
- Visit the official website: thereddyannabook.in
- Users can receive help from customer support staff through both WhatsApp and Telegram platforms.
- Users must submit their information along with making an initial funding transaction.
- Upon completion Reddy Anna Book gives users their Cricket ID and necessary login credentials.
- Rub on your gambling bets to enjoy your preferred athletic events and competitions.
Final Thoughts
Restaurant Anna Book delivers an excellent service experience to sports bettors who need secure betting and extensive gaming options. Reddy Anna Book delivers a solution that suits betters of every skill level including first-time participants and advanced players.
to know more visit:https://thereddyannabook.in/